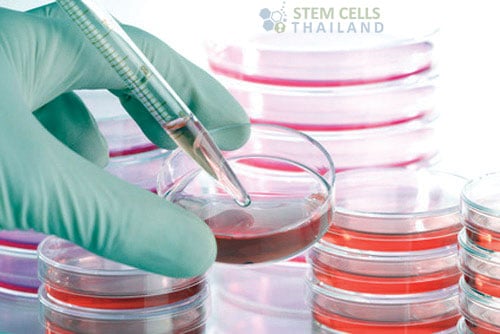

Culture medium also called growth medium pertains to the liquid medium necessary to carry out a culture and sensitivity test. The substance acts as a mode of support and nourishment for the cells undergoing culture, and may also contain growth factors necessary to generate cell change.
Request Information